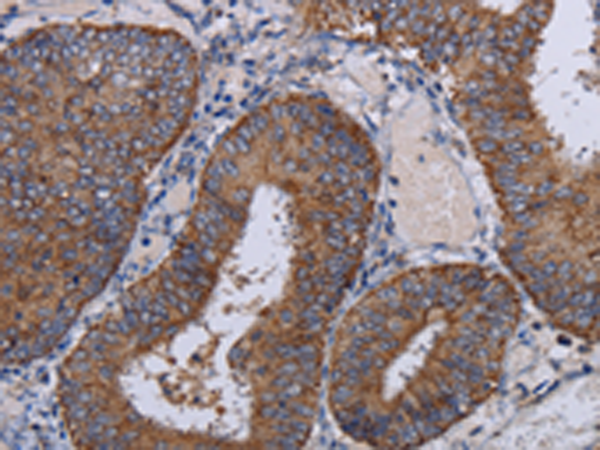

中文名稱: 兔抗NDUFA1多克隆抗體
英文名稱: Anti-NDUFA1 rabbit polyclonal antibody
別 名: MWFE; ZNF183; CI-MWFE
相關類別: 一抗
儲 存: 冷凍(-20℃)
宿 主: Rabbit
抗 原: NDUFA1
反應種屬: Human
標 記 物: Unconjugate
克隆類型: rabbit polyclonal
技術規(guī)格
|
Background: |
The human NDUFA1 gene codes for an essential component of complex I of the respiratory chain, which transfers electrons from NADH to ubiquinone. It has been noted that the N-terminal hydrophobic domain has the potential to be folded into an alpha-helix spanning the inner mitochondrial membrane with a C-terminal hydrophilic domain interacting with globular subunits of complex I. The highly conserved two-domain structure suggests that this feature is critical for the protein function and might act as an anchor for the NADH:ubiquinone oxidoreductase complex at the inner mitochondrial membrane. |
|
Applications: |
ELISA, IHC |
|
Name of antibody: |
NDUFA1 |
|
Immunogen: |
Fusion protein of human NDUFA1 |
|
Full name: |
NADH dehydrogenase (ubiquinone) 1 alpha subcomplex, 1, 7.5kDa |
|
Synonyms: |
MWFE; ZNF183; CI-MWFE |
|
SwissProt: |
O15239 |
|
ELISA Recommended dilution: |
2000-5000 |
|
IHC positive control: |
Human colon cancer and human brain |
|
IHC Recommend dilution: |
50-200 |
購物車
幫助
021-54845833/15800441009
